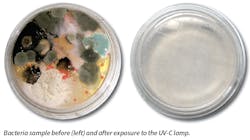
Www Hpac Com Sites Hpac com Files Uv C Clean Bacteria Samples Www Hpac Com Sites Hpac com Files Uv C Clean Bacteria Samples

Battling moisture, university finds UV fix
By DAN JONES, UV Resources, Santa Clarita CA
When your campus is home to 27,000 students, indoor air quality (IAQ) is of the utmost importance.
Located in Fayetteville, the University of Arkansas has 100 buildings served by approximately 150 air handling units (AHUs), each designed to condition and filter campus airstreams. Rick Gragg (pictured above), HVAC Coordinator with the university’s Utility Operations Facility Operation department, has supervised a decade-long mission to improve IAQ by retrofitting campus AHUs with ultraviolet germicidal irradiation (UVGI). The technology uses light in the ultraviolet-C (UV-C) spectrum to remove biological growth from HVAC equipment, thereby ensuring that safe and clean air is delivered to students and faculty.
“Moisture is an ever-present threat in air handlers because the evaporator coil operates at a temperature less than the dew point,” explains Gragg, a 35-year HVAC industry veteran. “As moisture is drawn out of the air to yield cooler temperatures to room occupants, the resulting condensation provides the perfect environment for mold and other harmful contaminants to flourish.”
With the goal of adopting a permanent disinfection solution, Gragg worked with a contractor to install UV-C lamps in a variety of HVAC systems that serve campus buildings. Over a multi-year period, test applications resulted in:
- Reduced HVAC energy use;
- Increased air flow;
- Reduced maintenance labor;
- Fewer incidences of water overflowing condensate pans and damaging nearby equipment.
This journey to improved IAQ began with the need to address a relatively simple, yet unsightly housekeeping issue.
Removing Biological Growth
In 2008, facilities personnel alerted Gragg to complaints about biological growth accumulation on the air distribution registers in the Health, Physical Education and Recreation Building (HPER). As this 100,000-square-foot space has a heavy concentration of student activity rooms, Gragg needed a remedy that could work in conjunction with the two AHUs, which produce a combined 42,000 CFM.
Seeking a more permanent solution than steam cleaning the air registers, Gragg turned to Dwight Bailey and Travis Collyar with North Little Rock-based Air Filter Systems.
According to Bailey, ultraviolet germicidal UV-C technology is a cost-efficient and lasting means to remove biological growth in HVAC cooling coils, plenum interiors, drain pans and air filters. Widely embraced in the 1990s to improve indoor air quality, the 253.7 nm germicidal wavelength reflects deep into the evaporator coil to systematically eliminate the buildup that mechanical and chemical washing often misses.
Once gone, biological growth is unable to regenerate as long as exposure to the germicidal wavelength remains intact. More importantly for Gragg was the fact that once biological growth was removed from the AHU, the same would be true for all registers, return grilles and ceiling diffusers.
Gragg decided the HPER building would be a good test application of the technology. Knowing university leadership needed real-time ROI data to warrant a campus-wide investment in UV-C technology, he funded several trial efforts through his own operational budget.
The first project was to have the contractor retrofit UV-C lights on two air handlers downstream of the coil that service the recreation building. The RLM Xtreme fixtureless UV-C lamp system, manufactured by Santa-Clarita, California-based UV Resources, was selected.
Neither one of the coils had been cleaned prior to adding UV-C, ensuring Gragg could attribute any system changes directly to the UV additions. The organic buildup on the coils had increased the system pressure drop, which reduced the volume of air passing over the coil, as well as decreased the heat transfer efficiency level. In other words, biofilms can be several millimeters thick and will “choke” an air handler’s ability to move air across the coil to the point of severely inhibiting system performance.
In fact, researchers have found that exposing a fouled cooling coil to UVGI resulted in a 10 percent decrease in pressure drop and a 14.55 percent increase in heat transfer coefficient at reference conditions.1
Over a three-month period of UV-C treatment, measurements at the HPER building revealed a coil pressure drop decrease from nearly 1.0 inches to less than 0.8 inches of static pressure. This 2/10th of an inch reduction in pressure drop meant that the AHU fan didn’t need to strain to draw air through the plenum, providing energy savings, in addition to disinfection.
“The higher pressure drop resulting from a dirty coil meant the AHU fans had to work harder to compensate for the coil’s diminished cooling capacity,” explains Gragg. “Once the coil was cleaned and returned to its original ‘as-built’ specification, the system did not need to consume as much energy. As a result, we could lower the brake horse power by 1.311 and save roughly $1,077 in annual energy costs.”
With concrete data in hand, Gragg was able to demonstrate to his university leadership how UV-C retrofits are a budget-saving investment.
Test: Condensate Overflow
In 2010, Gragg found his next UV-C test case in the campus’ Harmon Parking Garage AHU, which had a recurring issue with overflowing condensation pans. An algae-like growth had developed in the HVAC condensation tray —a common problem when standing water is untreated—and was viscous enough to clog the drain tube. Efforts to unclog the drain and kill the algae-like substance with chlorine tabs were not only ineffective but unintentionally corroded the metal drain pans. The resulting overflow of water cascaded into an IT network closet below the AHU, ruining sensitive electronic equipment.
Once again, Gragg turned to UV for a solution. The garage has four small DX AHUs with A-style coils. The coils are in a difficult location to manually clean, so the RLM Xtreme was added because of its flexible configurations. “Since the installation, there has not been an overflow problem reported because the UV-C light reflects to penetrate even the most hidden recesses in the system,” explains Bailey.
“We can attribute these results directly to the germicidal wavelength.”
Boosting Occupant Satisfaction
During routine service to the Arkansas Student Union in 2015, Gragg and his team had trouble opening one of the nine AHU doors that service the 228,000-square-foot facility. After dismantling the air handler, the team discovered such extensive grime buildup, that the fan’s negative pressure level had created a vacuum effect that “held” the AHU doors closed. Following an emergency steam cleaning of the coil, Gragg installed UV-C on five of the AHUs, three of which were 15 years old and two of which were brand new.
Within a month, Gragg heard from students and staff in the building that they could breathe easier and felt better. UV-C is scheduled to be added to the remaining AHUs serving the ARKU.
UV-C has proven to be effective in eliminating potential disease, the threat of which looms over highly populated areas such as university campuses. A 2013 CDC-funded study conducted in two hospitals found that UV-C reduced the total number of colony-forming units of any pathogen in a room by 91 percent. ASHRAE has also recommended use of UV-C in a position document on treating airborne infectious diseases.
Savings Over Steam Cleaning
In the HPER building in 2014, a second AHU unit had a severely clogged coil, preventing it from bringing in air at the designed 26,000 CFM. The buildup on the coil was thick enough that an immediate steam cleaning was necessary to restore its operation. After the steam cleaning restored the coil, UV-C was applied immediately afterward. Within several days, air flow levels through the coil increased 127.5 percent and have held at that level throughout the three years since its installation, Gragg reported. This demonstrated that applying UV-C after a manual cleaning keeps the coil depths clean and continuously ensures the AHU is operating at its design specification.
UV-C has an average installed cost of $0.15 per CFM, and many users report that their cost for an installed UV-C system featuring high output lamps was even less. “This upfront cost is a mere fraction of the 10-25 percent potential reduction in energy and maintenance costs UV-C offers,” says Bailey.
“The UV-C system is a one-time investment,” continues Bailey. “Alternative methods, such as mechanical cleanings, must be reapplied intermittently because, unlike UV-C, they are unable to eliminate the root source of contamination. As long as lamp changes are maintained, no future steam cleanings are required, saving on contractor and overtime costs. With UV-C, cooling coils will look as clean during year seven as on day one.”
Looking Toward the Future
His experience with UV-C technology in these applications convinced Gragg, and the university, that it would be an effective, worthwhile investment for all air handlers on campus. As a result, the university has continued to install the units—48 to date—across campus. The most recent application involves installing the technology in two air handling units in February 2018. No doubt, the university has found an HVAC/R cleaning solution that works and is sticking with it moving forward. In fact, it is standard practice now for the university to install UV lighting on all new air handlers.
____________________________
1. Firrantello, J.T., Bahnfleth, W. P., Montgomery, R., Kremer, P. K., “Field Study of Energy Use-Related Effects of Ultraviolet Germicidal Irradiation of a Cooling Coil,” 12th REHVA World Congress CLIMA 2016, May 22-25, 2016, Aalborg, Denmark.